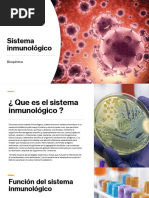

0% encontró este documento útil (0 votos)
208 vistas3 páginasEl Sistema Inmune
El documento explica el funcionamiento del sistema inmune. El sistema inmune está compuesto por células, tejidos y órganos que trabajan juntos para proteger el cuerpo de amenazas como bacterias, virus y otros organismos. Los leucocitos, incluyendo fagocitos y linfocitos, detectan y eliminan estas amenazas. El sistema inmune incluye tanto inmunidad innata como adquirida.
Cargado por
Steven PiscoyaDerechos de autor
© © All Rights Reserved
Nos tomamos en serio los derechos de los contenidos. Si sospechas que se trata de tu contenido, reclámalo aquí.
Formatos disponibles
Descarga como DOCX, PDF, TXT o lee en línea desde Scribd
0% encontró este documento útil (0 votos)
208 vistas3 páginasEl Sistema Inmune
El documento explica el funcionamiento del sistema inmune. El sistema inmune está compuesto por células, tejidos y órganos que trabajan juntos para proteger el cuerpo de amenazas como bacterias, virus y otros organismos. Los leucocitos, incluyendo fagocitos y linfocitos, detectan y eliminan estas amenazas. El sistema inmune incluye tanto inmunidad innata como adquirida.
Cargado por
Steven PiscoyaDerechos de autor
© © All Rights Reserved
Nos tomamos en serio los derechos de los contenidos. Si sospechas que se trata de tu contenido, reclámalo aquí.
Formatos disponibles
Descarga como DOCX, PDF, TXT o lee en línea desde Scribd